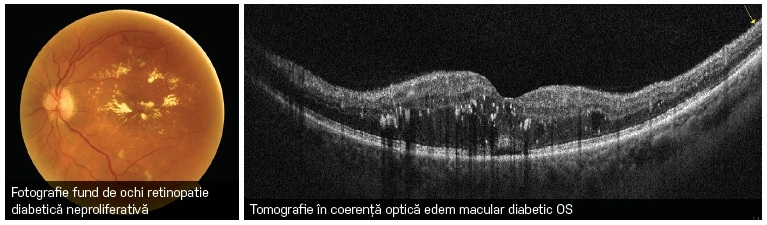
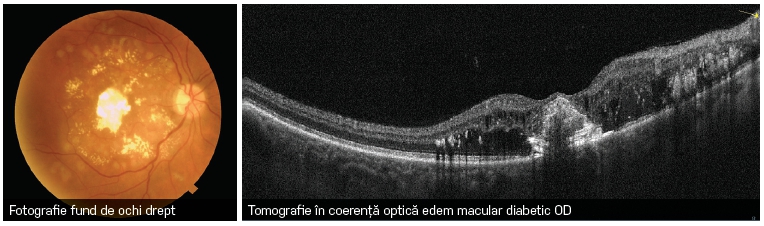

Prevenție și tratament
Retinopatia diabetică este o complicaţie frecventă a diabetului care are o prevalenţă de peste 33% printre pacienţii diabetici. În ţările dezvoltate, retinopatia diabetică este principala cauză de orbire la persoanele între 20 şi 65 ani. Datele statistice recente arată că majoritatea pacienţilor cu o vechime a diabetului de cel puţin 15 de ani dezvoltă retinopatie diabetică. Dintre aceştia, 10% prezintă forme de retinopatie diabetică ce ameninţă grav vederea.
Retinopatia diabetică are 2 forme distincte: forma neproliferativă şi forma proliferativă. Edemul macular este o complicaţie care poate apărea în fiecare din cele 2 forme.
În timp, diabetul afectează sistemul circulator al retinei. În faza inițială a bolii, numită neproliferativă, arterele care irigă retina se sparg, formând hemoragii, pereții vaselor capilare fragilizate permit ieșirea plasmei din vase în retină ceea ce duce la îngroșarea retinei numită edem macular. Pacientul sesizează vedere încețoșată, neclară, pete și sclipiri, estomparea culorilor și uneori deformarea obiectelor.
Următorul stadiu este cunoscut sub numele de retinopatie proliferativă. În acest stadiu, circulația retinei este dramatic afectată, lăsând zone lipsite de alimentarea cu oxigen (ischemice) care generează formarea unor noi vase anormale ce cresc pe suprafața retinei sau se extind în corpul vitros. Aceste vase foarte fragile generează rapid hemoragii, sângele se poate acumula la nivelul retinei sau poate umple cavitatea vitreană ceea ce duce la scăderea bruscă și totală a vederii.
Așadar, retinopatia proliferativă este faza cea mai de temut a bolii deoarece vasele noi anormale se extind progresiv, formează membrane neovasculare care pot produce dezlipirea de retină. Acest stadiu poate fi prevenit prin prezentarea pacientului la controale regulate și începerea medicamentului eficient care stopează evoluția bolii.
Factorii de risc pentru progresia retinopatiei diabetice sunt reprezentaţi de tipul diabetului zaharat, durata diabetului şi controlul metabolic de-a lungul anilor. Hipertensiunea arterială, dislipidemia, afectarea renală, anemia, fumatul, consumul exagerat de alcool constituie factori de risc suplimentari pentru agravarea retinopatiei diabetice.
Cea mai bună metodă pentru prevenirea orbirii este diagnosticul retinopatiei diabetice şi tratamentul leziunilor care pun în pericol vederea, înainte ca acuitatea vizuală să fie afectată. Acest obiectiv poate fi atins doar prin examinarea oftalmologică anuală a pacienților cu diabet. Consultația include anamneza cu depistarea factorilor de risc, determinarea acuităţii vizuale, presiunea
intraoculară şi examinarea fundului de ochi pe pupila dilatată, cu ajutorul lentilelor speciale şi fotografia digitală a retinei. Această examinare este obligatorie pentru orice pacient în momentul diagnosticării diabetului şi trebuie repetată anual.
În cazul depistării retinopatiei diabetice, recomandăm controalele oftalmologice la 3 sau 6 luni în funcție de tipul și gravitatea bolii. Retinopatia diabetică nu produce simptome vizuale atât timp cât aria maculară nu este implicată, de aceea atragem atenția că monitorizarea retinopatiei diabetice trebuie să fie un proces activ, unde pacientul are grijă să se prezinte anual la o consultație oftalmologică, înainte ca vederea să-i fie afectată.
Examinarea retinei este completată cu tomografia în coerență optică, investigație neinvazivă prin care se diagnostichează cu precizie edemul macular localizat sau difuz, membrane care pliază și deformează suprafața retinei, dezorganizând structura acesteia.
Angiografia OCT aduce informații suplimentare privind zonele de ischemie retiniană (absența capilarelor retiniene, factori de risc pentru evoluția către forma proliferativă a bolii).
Tratamentul
Retinopatia diabetică neproliferativă cu edem macular beneficiază de tratamentul modern prin injecții intravitreene cu medicamente care inhibă dezvoltarea de vase anormale (anti-VEGF) și reduc acumularea de lichid în straturile retinei, restabilind structura retiniană normală. Când edemul macular este localizat la distanță de centrul retinei, utilizăm tratamentul LASER prin fotocoagularea directă a microanevrismelor (dilatații capilare) responsabile de pierderea fluidelor care determină îngroșarea retinei.
Retinopatia diabetică proliferativă se tratează prin aplicații LASER pe toată periferia retinei (panfotocoagulare LASER)
combinată și cu injecții intravitreene cu agenți anti-VEGF
ce inhibă dezvoltarea vaselor de sânge anormale și previn complicații grave ca hemoragia vitreană și dezlipirea de retină. Aceste complicații, odată apărute, se tratează numai prin chirurgie vitreoretiniană.
Pentru prevenția retinopatiei diabetice, cel mai bun mijloc este tratamentul optim al diabetului, știind că pe termen lung hiperglicemia este factorul principal care contribuie la dezvoltarea unor complicații cronice, incluzând retinopatie, neuropatie și nefropatie care influențează negativ calitatea vieții pacienților cu diabet. Studiile arată că un control glicemic riguros (menținerea nivelului HbA1c la 6,5%) este eficient în reducerea incidenței complicațiilor la pacienții diabetici, asociată cu menținerea tensiunii arteriale la nivele sub 130 / 80 mmHg, a colesterolului și trigliceridelor cât mai apropiate de valorile normale.
Tratamentul diabetului și complicațiilor sale este o provocare majoră ce necesită o colaborare multidisciplinară, implicând specialistul de diabet, medicul de familie, medicul oftalmolog, medicul neurolog, medicul nefrolog. Doar printr-o colaborare strânsă între pacient și medicul său, se poate izbândi în lupta cu această complicaţie redutabilă, victoria fiind reprezentată de conservarea acuităţii vizuale, atât de utilă desfăşurării unei vieţi normale.



























